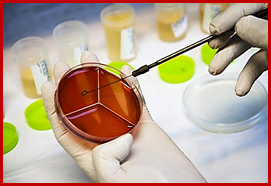

دستورالعمل جمع آوری نمونه جهت کشت ادرار در آقایان
1-بهترین نمونه جهت تشخیص عفونت های ادراری ، نخستین نمونه ادرار صبحگاهی است در صورت عدم امکان ، ادرار2 ساعت پس ار آخرین دفع گرفته شود.
2- بیمار تا 3روز قبل از کشت نباید داروهای آنتی بیوتیک مصرف کرده باشد.
3- دستهای خود را با آب و صابون شسته و خشک کنید.
4- سر آلت را با یک دستمال مرطوب تمیز کنید و دستمال را دور بیندازید و این کار را 2 بار تکرار کنید.
5- درب ظرف ادرار را با احتیاط باز کنید ، تحت هیچ عنوان دستهای شما نباید با سطح داخلی ظرف یا درب آن تماس پیدا کند.
6- مراقب باشید سر آلت به سطح داخلی ظرف نخورد.
7- مقدار کمی از قسمت اول ادرار (2ثانیه اول) را داخل توالت بریزید و قسمت میانی ادرار (حدود 30 میلی لیتر یا حداقل نصف ظرف نمونه) را داخل ظرف بریزید و بقیه را داخل توالت بریزید.
8- درب ظرف نمونه را بسته و تحویل آزمایشگاه بدهید.
9- در صورتیکه نمونه خارج از آزمایشگاه تهیه می شود لازم است به سرعت به آزمایشگاه ارسال شود و تا آن زمان در جای خنک نگهداری شود .